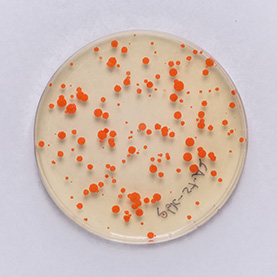
Original
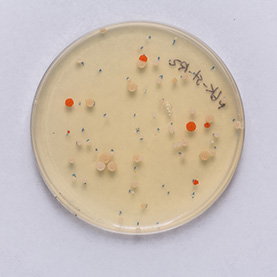
Original

CURATED BY
Julia Pollack
WHEN
April 29 - April 29
WHERE
Springer Cultural Center
View Gallery
1
/
10

Many processes within the body are changed by the presence of cancer. These images show the response of microglia, immune defense cells in the brain, to cancer cells. When microglia encounter glioblastoma multiforme, one of the most aggressive brain cancers, they shift from a relaxed, elongated shape to a rounded, ready-for-combat conformation.
These images echo the work of Anna Atkins, a British botanist and photographer who used a contact printing technique called cyanotyping to capture the form of plants and algae. Emily Chen’s work similarly seeks to explore biological function, in this case the immune response to brain cancer, by capturing and comparing biological forms.



Rock is often used to symbolize permanence, yet the structure of rock is constantly evolving, often on a spatial scale too small and a time scale too long for us to easily appreciate. By viewing cross-sections of sedimentary stone through a microscope, we can read the history of its incremental formation like the rings of a tree.
Here, this technique has been applied to a kidney stone that spontaneously formed in the body of a patient. Scientists were able to rewind the process through which three stones fused together to make one. By merging the geological knowledge of rock formation with the medical science of kidney stone prevention, they have developed a powerful new approach for addressing a common and painful disease.


Photosynthesis allows plants to convert sunlight and carbon dioxide into sugar. In many crop plants, photosynthesis becomes more inefficient as temperatures rise. If scientists can reclaim some of this lost energy, we may be able to move closer to global food security for our growing population even as the climate changes.
To explore the relationships among temperature, photosynthetic efficiency, and plant growth, researchers have compared plant yield when the growing temperature is raised by five degrees Celsius to the yield achieved in current ambient conditions. This composite image portrays the loss of yield caused by the higher temperature.




Our bodies have an impressive capacity to heal themselves; unfortunately, the nervous system regenerates much less easily than other vital tissues. Implants of materials that can support or guide the regrowth of cells could help the nervous system recover from injury or disease.
These images reveal the efforts of researchers to coax rat brain cells to grow across a surface of graphene, a material chosen for its toughness, flexibility, and ability to conduct electrical signals. The cells cannot easily implant on the graphene, and in early trials clung to each other instead. In later trials, the addition of the right mix of proteins to the graphene surface enabled cells to implant, grow, and form a healthy, web-like network.


The liver is a remarkable organ that deactivates toxins, aids in the digestive process, and can regenerate after a loss of as much as 75 percent of its tissue. Liver fibrosis is a condition in which liver tissue is chronically inflamed, resulting in scarring that can lead to liver cancer or liver failure. Researchers are studying the growth pattern of liver cells in different microenvironments to understand how to better treat this condition.
In this image, liver cell growth patterns were used to recreate the myth of Prometheus in the style of a Greek Laconian vase painting. As a punishment for bringing the innovation of fire to humankind, Prometheus was held captive as his liver was consumed by an eagle each day, recovering each night only to be consumed once again. This image draws a line between a knowledge of bodies that stretches back millennia and the modern scientific goal to convert suffering to healing.


Pathogens are a major factor affecting the evolution of primates. We know very little about how historical pandemics have affected the genomes of different populations. This image results from research that examines how genetic variation and historical exposure to one of the most virulent pathogens known in human history, the plague, has affected immune system evolution and human health.
In the center of this image we see human white blood cells (labeled blue) confronted with bacteria. To protect the body from this invader, the cells capture the bacteria by throwing nets made from their own DNA. The cells are laid over tracks that evoke those seen in bubble chambers, another innovation used by researchers to see into the smallest spaces and understand movement and action on the smallest scales.


As researchers search for promising sources of sustainable energy, attention has turned to an unassuming and ubiquitous member of the plant family: grass. Now, careful work is cataloging the qualities and strengths of different types of grass to identify the most desirable traits for a future biofuel crop.
The silhouettes in this image were derived from the cross-section of a single leaf, allowing plant scientists to analyze its internal structures and compare different types of energy crops. These shapes have been combined with views from the sky and the earth, which are the plant’s sources of nutrients as it grows a scaffold that may in turn help support our society.


Individuals with autism experience and interact with the world differently than those without autism. Researchers use imaging methods to explore structural brain differences in humans with autism and in animal models to help identify signatures of the condition. Identifying such signatures may allow the development of improved diagnostics and treatments for autism patients.
This triptych shows three views of the folds of a mouse cerebellum, a part of the brain that helps control fine motion. In this form of artwork, the three panels create a story by highlighting a central figure with supporting imagery to either side. This triptych highlights the use of different stains for different features: yellow for the DNA inside brain cells, blue for support cells surrounding neurons. By layering multiple stains, researchers can understand how those elements interact in living tissues.


Yeasts that can produce significant quantities of oil are promising candidates to use for production of biofuels and other useful chemicals, allowing for sustainable, environmentally friendly production of these compounds from biomass.
These images, crafted in the style of Hilma af Klint, compare a yeast that naturally produces the reddish pigment beta-carotene with its gene-edited cousin that has been modified to lose this capability. This work demonstrates the opportunity to guide and design the molecular activities of yeast. Like Klint’s use of geometrical shapes, these spheres of growth invite us to see a tiny universe of possibility and exploration in simple, everyday scientific objects.

Many different disorders and health conditions are diagnosed by accurately detecting the presence or quantity of a compound or molecule in a blood sample. The invention of faster, cheaper, or more portable devices empowers health providers and diverse populations to make health care more accessible.
One such device now in development uses a surface made of photonic crystal, a substance that alters the flow of light in the same way as the iridescent scales on a butterfly’s wing. This simulation shows how the presence of a tiny particle on such a detecting surface influences that flow of light. The design of this piece is a reminder of the dimensionality of light’s movement and the power of visual information.



Honey bee pollination helps to ensure the availability of many agricultural crops. Food security is threatened by a worldwide decline in honey bee populations due to four main factors: parasites, pathogens, pesticides, and poor nutrition. Scientists are currently developing and using new techniques study honey bee reproduction and development in order to identify ways to mitigate these four factors.
This image shows a honey bee larva reared from an egg in a specialized artificial honeycomb plate, using a robotic system that allows scientists to study the growth and development of honey bees from embryos to adults under tightly controlled laboratory settings. The scale of the image places the viewer in the role of a nurse bee checking to see whether the larva is healthy and fed.


Genome editing holds immense promise in revolutionizing all aspects of medicine and many other industries. By understanding how gene editing proteins behave inside the cell at the single molecule level, researchers can gain insights into designing highly specific technologies.
CRISPR has been deservedly recognized as an efficient way to edit DNA, but scientists have other strategies to choose from. TALE molecular pathways are more accurate than CRISPR in their identification of DNA sites to be edited. This image evokes the precise pathways taken by the TALE molecules along strands of DNA in living cells.

As atmospheric ozone concentration changes, we need to improve our understanding of the way that plants acquire and retain their nutrients in different conditions so we can continue to grow and harvest crops for our survival. Many studies have only modeled the impacts of ozone on species such as maize; fewer have directly quantified physiological and biochemical responses to ozone stress in maize.
This image represents a larger project that uses a multifaceted approach to understand the physiological and biochemical responses of maize grown under elevated ozone. The spots of blue were generated by a lab procedure that measures phenolic content—the presence of important plant compounds—in samples of maize. The burned out wood in the background resembles a desert, once-living plant matter that has lost many of its nutrients.


When a cell divides to make two daughter cells, it must first replicate its DNA. The entire genome is not replicated simultaneously; instead, there is a defined order in which different segments of DNA will be copied. This order relates to the functions of genes within those segments and can be disrupted by diseases such as cancer.
Researchers have developed a new method of tracking, in real time, the replication of specific genes inside living cells. This image shows yellow dots, the cell’s DNA replication machinery, converging on green dots that mark the locations of a gene of interest. The moment of overlap marks the time of replication. This piece relates the twists and curls of living genomic DNA to the pathways of a labyrinthine garden, conveying a sense of space within the creation of a new world of DNA.


Honey bees are the most important pollinator on the planet, but bee health is seriously threatened by many interacting factors. Current bee health research seeks to clarify how social interactions among honey bees enable their colony to respond to disease, which may lead to better colony management practices and increased food security.
Each Polaroid in this piece shows a group of interacting honey bees wearing miniature barcodes. These images were cropped from a much larger photo of an entire bee colony that was continuously monitored to increase our knowledge of bee social networks. The aesthetics of this piece reference Hanne Darboven, an artist whose work helped the viewer see time through hand-drawn calendars and numbers. As humans we feel an aversion to swarming behavior, but by looking closely and highlighting their interactions, we begin to see the lives of bees as individuals and communities.




In an effort to understand the complex processes of the brain, researchers are leveraging novel imaging technologies to create increasingly detailed models of brain structure. The images seen in this piece were created when researchers repeatedly imaged the surface of a sample of brain tissue from a young pig, then removed a thin layer of tissue before imaging again. The extended projections of neurons, called axons, appear as dark rings. One axon is highlighted in red.
This serial imaging produces images that enable the viewer to construct an idea of the true shape of the tissue. Each slice that is removed adds a new layer of information to the growing model; thus two dimensional objects grow into structures that can be traced through three dimensional space.




Influenza virus remains a major threat to public health. During an infection, the virus produces defective interference particles, smaller versions of the virus that disrupt the parent virus’ harmful activity. Researchers are studying the possibility of using these particles to develop a more sustainable and efficient vaccine.
This piece highlights the degradation of the viral genome as it replicates, as well as the different propagation rates of different variants. Researchers do not know why these rates vary; they are exploring this and other questions about the life cycle of influenza. Notice how movement near this piece provokes a dynamic response of the influenza particles that reflects the dynamic nature of flu’s presence inside the body.







Many different disorders and health conditions are diagnosed by accurately detecting the presence or quantity of a compound or molecule in a blood sample. The invention of faster, cheaper, or more portable devices empowers health providers and diverse populations to make health care more accessible.
One such device now in development uses a surface made of photonic crystal, a substance that alters the flow of light in the same way as the iridescent scales on a butterfly’s wing. This simulation shows how the presence of a tiny particle on such a detecting surface influences that flow of light. The design of this piece is a reminder of the dimensionality of light’s movement and the power of visual information.
The installation of this piece included 3D glasses for the viewers to so the nanoparticles dimensionally pop from the surface of the work, as well as an actual photonic crystal framed.
First Impressions
Scientist Collaborator
Jee-Wei and Emily Chen
Brendan Harley Laboratory
Instrument
Zeiss LSM 710 Confocal Microscope
Funding Agency
National Institutes of Health
Original Imaging


Special Thanks
Nelson family and BodyWork Associates; Champaign Park District
Image Rights
Images not for public use without permission from the Carl R. Woese Institute for Genomic Biology
Scientist Collaborator
Mayandi Sivaguru and Jessica Saw
Bruce Fouke Laboratory
Instrument
Zeiss LSM 880 Confocal Microscope
Funding Agency
Mayo Clinic & Illinois Alliance
Mayo Clinic
NASA
Original Imaging

Special Thanks
Nelson family and BodyWork Associates; Champaign Park District
Image Rights
Images not for public use without permission from the Carl R. Woese Institute for Genomic Biology
Scientist Collaborator
Amanda Cavanagh
Donald Ort and Carl J. Bernacchi Laboratories
Instrument
FLIR T1030sc Infrared Camera
Funding Agency
Bill & Melinda Gates Foundation
Foundation for Food and Agriculture Research
UK Department for International Development
Original Imaging


Special Thanks
Nelson family and BodyWork Associates; Champaign Park District
Image Rights
Images not for public use without permission from the Carl R. Woese Institute for Genomic Biology
Scientist Collaborator
Ellen Qin
Hyunjoon Kong Laboratory
Instrument
Zeiss LSM 700 Confocal Microscope
Funding Agency
National Science Foundation
Original Imaging


Special Thanks
Nelson family and BodyWork Associates; Champaign Park District
Image Rights
Images not for public use without permission from the Carl R. Woese Institute for Genomic Biology
Scientist Collaborator
Ishita Jain ( soft paper)
Gregory Underhill Laboratory
Instrument
Zeiss Axioscan Z1 Widefield Fluorescence Microscope
Funding Agency
National Institutes of Health
Original Imaging

Special Thanks
Nelson family and BodyWork Associates; Champaign Park District
Image Rights
Images not for public use without permission from the Carl R. Woese Institute for Genomic Biology
Scientist Collaborators
Katie Van Etten and Jessica Brinkworth
Jessica Brinkworth Laboratory
Instrument
Zeiss LSM 700 Confocal Microscope
Funding Agency
National Science Foundation
Original Imaging


Special Thanks
Nelson family and BodyWork Associates; Champaign Park District
Image Rights
Images not for public use without permission from the Carl R. Woese Institute for Genomic Biology
Scientist Collaborator
Shaojun Li
DK Lee Laboratory
Instrument
Zeiss 710 Multiphoton Microscope
Funding Agency
Department of Energy
Original Imaging

Special Thanks
Nelson family and BodyWork Associates; Champaign Park District
Image Rights
Images not for public use without permission from the Carl R. Woese Institute for Genomic Biology
Falling Into Place
Scientist Collaborator
Christopher Seward
Lisa Stubbs Laboratory
Instrument
Zeiss 710 Multiphoton Microscope
Funding Agency
National Institutes of Health
Original Imaging



Special Thanks
Nelson family and BodyWork Associates; Champaign Park District
Image Rights
Images not for public use without permission from the Carl R. Woese Institute for Genomic Biology
Scientist Collaborator
Carl Shultz (soft paper)
Huimin Zhao Laboratory
Instrument
Canon EOS 5D Camera
Funding Agency
Department of Energy
Original Imaging

Special Thanks
Nelson family and BodyWork Associates; Champaign Park District
Image Rights
Images not for public use without permission from the Carl R. Woese Institute for Genomic Biology
Scientist Collaborators
Taylor Canady and Nantao Li
Brian Cunningham Laboratory
Instrument
Photonic Resonance Absorption Microscope
Funding Agency
National Institutes of Health
Carl R. Woese Institute for Genomic Biology
Original Imaging


Special Thanks
Nelson family and BodyWork Associates; Champaign Park District
Image Rights
Images not for public use without permission from the Carl R. Woese Institute for Genomic Biology
Scientist Collaborators
Julia Fine, Julia Pollack, and Kendall Torres
Gene Robinson Laboratory
Instrument
Zeiss Axiozoom V16 Microscope
Funding Agency
Department of Defense
Original Imaging

Special Thanks
Nelson family and BodyWork Associates; Champaign Park District
Image Rights
Images not for public use without permission from the Carl R. Woese Institute for Genomic Biology
Planisphere
Scientist Collaborator
Surbhi Jain
Huimin Zhao Laboratory
Instrument
Nikon Ti Eclipse Microscope
Funding Agency
National Institutes of Health
Original Imaging

Special Thanks
Nelson family and BodyWork Associates; Champaign Park District
Image Rights
Images not for public use without permission from the Carl R. Woese Institute for Genomic Biology
Scientist Collaborator
Nicole Choquette
Lisa Ainsworth Laboratory
Instrument
Canon EOS 5D Camera
Funding Agency
National Science Foundation
Original Imaging

Special Thanks
Nelson family and BodyWork Associates; Champaign Park District
Image Rights
Images not for public use without permission from the Carl R. Woese Institute for Genomic Biology
Scientist Collaborator
Ipek Tasan
Huimin Zhao Laboratory
Instrument
DeltaVision OMX Superresolution Microscope
Funding Agency
National Institutes of Health
Original Imaging

Special Thanks
Nelson family and BodyWork Associates; Champaign Park District
Image Rights
Images not for public use without permission from the Carl R. Woese Institute for Genomic Biology
Scientist Collaborator
Tim Gernat
Gene Robinson Laboratory
Instrument
Allied Vision Technologies Prosilica GT6600 with a Schneider Kreuznach Macro Apo-Componon 4.5/90 lens
Funding Agency
National Science Foundation
National Institutes of Health
Christopher Foundation
National Academies Keck Futures Initiative
Original Imaging

Special Thanks
Nelson family and BodyWork Associates; Champaign Park District
Image Rights
Images not for public use without permission from the Carl R. Woese Institute for Genomic Biology
Scientist Collaborators
Kingsley Boateng, Stephen Fleming, and Ryan Dilger
Ryan Dilger Laboratory
Instrument
Zeiss Sigma BP 3View Serial Block Face Scanning Electron Microscope
Funding Agency
Carl R. Woese Institute for Genomic Biology
Original Imaging

Special Thanks
Nelson family and BodyWork Associates; Champaign Park District
Image Rights
Images not for public use without permission from the Carl R. Woese Institute for Genomic Biology
Scientist Collaborator
Fadi Alnaji
Christopher Brooke Laboratory
Instrument
3D Visualization and analysis software
Funding Agency
U.S. Department of Defense
Original Imaging

Special Thanks
Nelson family and BodyWork Associates; Champaign Park District
Image Rights
Images not for public use without permission from the Carl R. Woese Institute for Genomic Biology
Scientist Collaborator
Taylor Canady and Nantao Li
Brian Cunningham Laboratory
Instrument
Photonic Resonance Absorption Microscope
Funding Agency
National Institutes of Health
Carl R. Woese Institute for Genomic Biology
Original Imaging



Special Thanks
Nelson family and BodyWork Associates; Champaign Park District
Image Rights
Images not for public use without permission from the Carl R. Woese Institute for Genomic Biology
Special Thanks
Champaign businessman Doug Nelson, President of BodyWork Associates, first proposed the idea that became Art of Science, and his continued efforts to support the exhibit made its realization possible. The IGB is also grateful to James Barham of Barham Benefit Group and [co][lab] founder Matt Cho for hosting the annual exhibit.